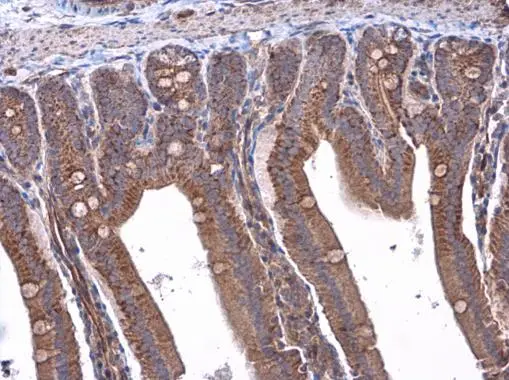
RAB39B antibody detects RAB39B protein at cytoplasm in mouse duodenum by immunohistochemical analysis. Sample: Paraffin-embedded mouse duodenum. RAB39B antibody (GTX118261) diluted at 1:500. 
 Antigen Retrieval: Citrate buffer, pH 6.0, 15 min

The image on the left is immunohistochemistry of paraffin-embedded Human thyroid cancer tissue using CSB-PA112057(RAB39B Antibody) at dilution 1/45, on the right is treated with synthetic peptide. (Original magnification: x200)
RAB39B Antibody
CSB-PA112057
ApplicationsELISA, ImmunoHistoChemistry
Product group Antibodies
ReactivityHuman, Mouse
TargetRAB39B
Overview
- SupplierCusabio
- Product NameRAB39B Antibody
- Delivery Days Customer20
- ApplicationsELISA, ImmunoHistoChemistry
- CertificationResearch Use Only
- ClonalityPolyclonal
- ConjugateUnconjugated
- Gene ID116442
- Target nameRAB39B
- Target descriptionRAB39B, member RAS oncogene family
- Target synonymsBGMR, MRX72, WSMN, WSN, XLID72, ras-related protein Rab-39B, Waisman syndrome
- HostRabbit
- IsotypeIgG
- Protein IDQ96DA2
- Protein NameRas-related protein Rab-39B
- Scientific DescriptionThis gene encodes a member of the Rab family of proteins. Rab proteins are small GTPases that are involved in vesicular trafficking. Mutations in this gene are associated with X-linked mental retardation.
- ReactivityHuman, Mouse
- Storage Instruction-20°C or -80°C
- UNSPSC41116161